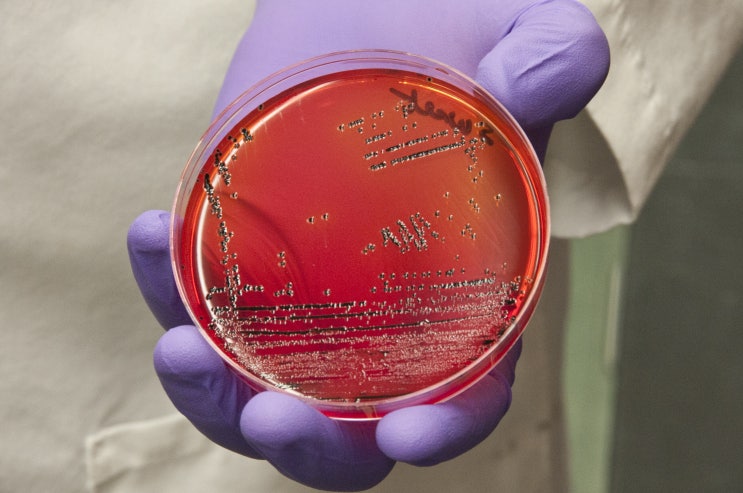

어린이 수족구병, 초기 증상과 대처 방안에 대하여
2025.10.04

요즘 들어 수족구병과 관련된 이야기들이 여기저기에서 들려오고 있습니다. 실제로 발병되는 경우도 많고, ...
출처
https://blog.naver.com/juno5733/221690398733
이슈모어 핫이슈
-
 장동윤, 감독으로 부천行…‘누룩’ 초청에 SNS 일상까지 화제
배우 장동윤이 연출자로 또 한 번 이름을 올렸다. 두 번째 연출작 영화 ‘누룩’이 부천국제판타스틱영화제에 초…
장동윤, 감독으로 부천行…‘누룩’ 초청에 SNS 일상까지 화제
배우 장동윤이 연출자로 또 한 번 이름을 올렸다. 두 번째 연출작 영화 ‘누룩’이 부천국제판타스틱영화제에 초…
-
 주지훈·하지원·나나·차주영·오정세 총출동… 권력의 정점에서 터지는 ENA ‘클라이맥스’
ENA 새 드라마 클라이맥스가 1차 티저 공개와 함께 본격적인 기대감을 끌어올리고 있다. 권력의 최정점에서 …
주지훈·하지원·나나·차주영·오정세 총출동… 권력의 정점에서 터지는 ENA ‘클라이맥스’
ENA 새 드라마 클라이맥스가 1차 티저 공개와 함께 본격적인 기대감을 끌어올리고 있다. 권력의 최정점에서 …
-
 “이민기 귀환, 곽선영 합류”… ENA ‘크래시2’ 더 거칠어진 도로 위 수사전 예고
ENA가 2026년 하반기 편성을 확정한 드라마 크래시2가 본격적인 시동을 걸었다. ‘분노의 도로’라는 부제…
“이민기 귀환, 곽선영 합류”… ENA ‘크래시2’ 더 거칠어진 도로 위 수사전 예고
ENA가 2026년 하반기 편성을 확정한 드라마 크래시2가 본격적인 시동을 걸었다. ‘분노의 도로’라는 부제…
관련 포스팅
Copyright blog.dowoo.me All right reserved.